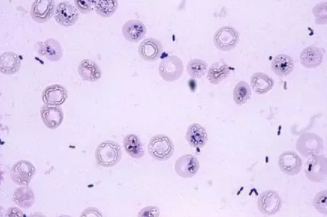
新生兒敗血癥怎么治療   寶寶敗血癥治療方法

時間:2018-10-26 13:50:12來源:本站整理作者:fangyu點擊:
新生兒因為免疫系統差,感染了敗血癥很容易全身擴散,需要及時的就醫治療,早日恢復健康,那么新生兒敗血癥怎么治療?下面八寶網小編帶來介紹。

1.抗生素治療
依據細菌培養結果和藥物敏感試驗選用抗生素。
用藥原則:早用藥,合理用藥,聯合用藥,靜脈給藥。療程足,注意藥物毒副作用。
2.處理嚴重并發癥
監測血氧和血氣,及時糾正酸中毒和低氧血癥,北京張博士醫考中心搜集|整理及時糾正休克,積極處理腦水腫和DIC.
3.清除感染灶。
4.支持療法
注意保溫,供給足夠熱卡和液體。糾正酸中毒和電解質紊亂。
5.免疫療法
靜脈注射免疫球蛋白。
敗血癥是由致病菌感染擴散至全身血液引起的,想預防敗血癥,一定要盡量避免感染。
3歲以下的孩子皮膚尚未發育完全,皮膚屏障比較薄弱,一定要注意避免皮膚損傷,防止致病菌通過孩子的皮膚黏膜引起感染。父母可以這樣來保護孩子的皮膚:
經常給孩子到戶外活動。借助陽光中的紫外線殺滅孩子體表的病菌,增強孩子皮膚的堅韌性,幫孩子提高免疫力。
經常給孩子洗溫水澡。經常洗澡(每周2次以上)可以清除孩子皮膚表面的病菌和污垢,促進血液循環,保護上皮組織細胞,增強孩子皮膚的防御能力。

孩子的衣著應柔軟、寬松。質料粗糙、剪裁過緊的衣褲容易使孩子的皮膚受到摩擦,從而引起破損和感染。
不要讓孩子玩有尖角的玩具或棍棒,以防戳破孩子的皮膚,引起病菌侵入而發病。
以上就是新生兒敗血癥怎么治療,寶寶敗血癥治療方法,請大家繼續關注。
網友跟帖
Copyright 2015-2020 8bb.com 〖八寶網〗 版權所有 鄂ICP備19016373號-1
聲明: 本站文章均來自互聯網,不代表本站觀點 如有異議 請與本站聯系 本站為非贏利性網站 不接受任何贊助和廣告
網友評論僅供其表達個人看法,并不表明八寶網立場。